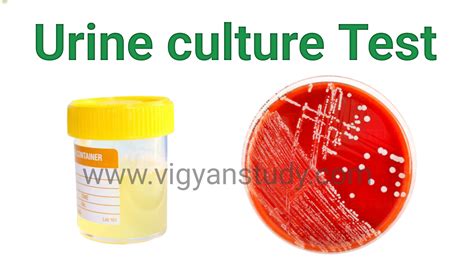

PSEIAFBSE Culture Test: A Comprehensive Guide In Hindi
PSEIAFBSE Culture Test: A Comprehensive Guide in Hindi
Hey guys! Are you ready to dive into the fascinating world of the PSEIAFBSE culture test? If you’re looking to understand this test in Hindi, you’ve come to the right place. This guide will break down everything you need to know in a friendly and easy-to-understand way. Let’s get started!
Table of Contents
What is the PSEIAFBSE Culture Test?
So, what exactly is the PSEIAFBSE culture test? Understanding the fundamentals is crucial before diving deeper. The PSEIAFBSE culture test, although it sounds complex, is essentially a tool used to assess and understand various cultural dimensions within a group or organization. It helps in identifying the prevailing values, beliefs, and behaviors that shape the environment. The acronym itself may represent different aspects or categories evaluated within the test, such as Personal Style, Ethical Standards, Innovation Approach, etc. The exact meaning of each letter can vary depending on the specific context or the organization administering the test. This test plays a vital role in fostering better communication, collaboration, and overall cultural alignment. It’s not just about ticking boxes; it’s about gaining genuine insights into what makes a culture tick. When administered and interpreted correctly, the PSEIAFBSE test can highlight areas of strength and opportunities for improvement. Organizations often use these tests during mergers, acquisitions, or large-scale transformations to ensure a smooth cultural integration. Moreover, this assessment provides a framework to address potential cultural clashes, which, if left unattended, can lead to decreased productivity and morale. It’s all about creating an environment where everyone feels understood and valued, regardless of their background or perspective. Keep reading to learn more about how this test is used and why it matters!
Why is Cultural Assessment Important?
Cultural assessment is super important because it helps us understand the unspoken rules and values that drive behavior within a group or organization. Think of it as the DNA of a company or community . Without understanding this DNA, it’s tough to build a cohesive and productive environment. Cultural assessments like the PSEIAFBSE test provide a structured way to evaluate these elements. By identifying the dominant cultural traits, organizations can better align their strategies, improve communication, and foster a sense of belonging. In today’s globalized world, where teams are often diverse and spread across different locations, the significance of cultural alignment cannot be overstated. A cultural assessment helps bridge gaps and ensure that everyone is on the same page, working towards common goals. Ignoring cultural nuances can lead to misunderstandings, conflicts, and ultimately, a decline in performance. Companies that prioritize cultural assessment are more likely to attract and retain top talent, as employees feel valued and understood. It also promotes innovation and creativity, as diverse perspectives are welcomed and integrated. Furthermore, understanding the cultural landscape helps in mitigating risks associated with ethical lapses or compliance issues. A strong, positive culture built on shared values is a powerful defense against misconduct. Cultural assessment is not just a one-time exercise; it should be an ongoing process, adapting to the evolving needs of the organization and its people. It’s about creating a culture of continuous improvement, where feedback is encouraged, and everyone feels empowered to contribute their best. So, whether you’re a leader, an HR professional, or an employee, understanding the importance of cultural assessment is key to building a thriving and successful organization.
Key Components of the PSEIAFBSE Test
Alright, let’s break down the key components of the PSEIAFBSE test. Each letter in PSEIAFBSE represents a different dimension of cultural assessment . These components help to create a comprehensive profile of the cultural landscape being evaluated. For instance, ‘P’ might stand for Personal values, assessing the individual beliefs and principles that guide behavior. ’S’ could represent Social norms, examining the unwritten rules and expectations within the group. ‘E’ might denote Ethical standards, evaluating the moral principles that govern decision-making. ‘I’ could stand for Innovation orientation, assessing the group’s openness to new ideas and change. ‘A’ might represent Achievement focus, evaluating the emphasis on goals and results. ‘F’ could denote Flexibility, assessing the group’s ability to adapt to changing circumstances. ‘B’ might represent Belonging, evaluating the sense of community and inclusion. ’S’ could represent Structure, evaluating the hierarchy and organization of the company. And finally, ‘E’ might denote Engagement, evaluating how motivated the employees are. Each of these components is evaluated through a series of questions or scenarios designed to elicit responses that reveal underlying cultural values and beliefs. The responses are then analyzed to identify patterns and trends, providing insights into the dominant cultural traits. Understanding these components is crucial for interpreting the test results and developing strategies to address any identified cultural gaps or challenges. It’s important to note that the specific meaning of each letter can vary depending on the context, but the underlying principle remains the same: to provide a structured and comprehensive assessment of the cultural landscape. By understanding these components, you can gain a deeper appreciation for the nuances of culture and its impact on organizational performance.
How to Prepare for the PSEIAFBSE Test
Getting ready for the PSEIAFBSE test ? Don’t sweat it! Preparation is key , and there are several things you can do to approach the test with confidence. First and foremost, familiarize yourself with the purpose of the test. Understanding why the assessment is being conducted and what the organization hopes to achieve will help you answer the questions more thoughtfully. Research the company’s values and mission statement to get a sense of the desired cultural traits. Reflect on your own values and how they align with the organization’s stated values. This doesn’t mean you should try to fabricate your responses, but rather, be mindful of how your personal values might contribute to the overall cultural landscape. Practice active listening and try to understand the perspectives of others. Culture is a collective phenomenon, and your ability to empathize and appreciate different viewpoints will be valuable. If possible, talk to colleagues or friends who have taken similar cultural assessments to get insights into the types of questions asked and the overall experience. When taking the test, be honest and authentic in your responses. Avoid trying to guess what the